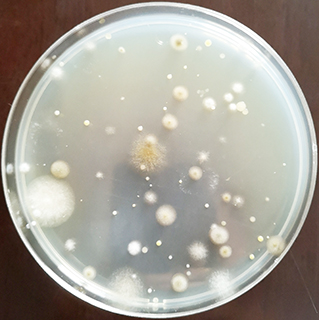
◎ 用沙氏培養基平板佈點得出的菌落。

承上文。以浙江某庫房為例,治理前的PM2.5實測為每立方米廿五微克,有害微生物採用自然降落法,用九厘米沙氏培養基(Sabouraud medium)平板進行佈點,得出每培養皿約八個菌落(見附圖)。而經「高壓靜電複合柱極絕緣體治理裝置」處理後,PM2.5降為每立方米一點六九微克,去除率達百分之九十三;有害微生物降到每培養皿一個菌落,滅菌率約為百分之九十,個別培養皿甚至達到無菌落的潔淨狀態,符合中國藥品生產潔淨室空氣潔淨度標準。此外,可揮發性有機化合物(VOCs)治理前、後濃度的改變如下表,其去除率介乎百分之二至五十八不等。
不論是新建、還是老舊的庫房,只要其溫濕度系統屬於集中送風方式,均可把「高壓靜電複合柱極絕緣體治理裝置」安裝於空調的回風口,就可有效消除空氣中各種不同的污染物。當前,許多庫房均安裝有鮮風系統,故也可透過增加鮮風量來降低室內空氣污染物的濃度;當然,從戶外導入的鮮風需預先經過處理才能吹進庫房,這包括調整空氣的溫度、相對濕度、除塵、滅菌及去除各種有機化合物(如:汽車排出的廢氣)等。為此,「高壓靜電複合柱極絕緣體治理裝置」可安裝在鮮風機的管道內來配合空氣淨化,從而保證輸入庫房的鮮風不帶有危害工作人員健康及文獻檔案保護的污染物。
當前,針對受蟲害影響的文獻,檔案工作者較常採用真空充氮或低溫冷凍法進行殺滅處理,但對於有害的微生物和病毒,此兩方法均無甚效果,除非使用一定濃度的乙醇(酒精)、過氧化氫(雙氧水)或次氯酸鈉(漂白水)等消毒劑,則可在數分鐘內有效消滅。據專家指出,目前正肆虐的新型冠狀病毒肺炎,在空氣中的存活時間有限,但當沉降在物體表面後,則可存活數小時至九天不等,以紙質文獻載體為例,其存活時間約為三至四天。當疫情回復平穩,文獻檔案館恢復對外提供利用時,筆者建議,文獻檔案工作者應注意以下幾個方面:
一)保持良好和健康的心態,日常工作要謹記配戴口罩、勤洗手。
二)因病毒在空氣和物體表面存活一段時間後便會自動失活,故病毒對文獻和檔案載體的影響可以忽略不計;至於收進庫房的文獻和檔案,只要存放時間超過九天,基本上沒有必要採取任何針對性的消毒措施。
三)對借閱歸還的文獻及檔案,若果不需要馬上借出,就不必進行消毒處理;假如需要消毒,對耐熱物品可採用紅外輻射乾燥加熱方式進行處理,而閱覽室等場所則可使用一定濃度的過氧化氫或次氯酸鈉對物件表面進行消毒。
四)大多數消毒劑均會對文獻及檔案造成破壞,因此,絕不能直接使用。
五)紫外線可對空氣進行消毒,但不能直接照射文獻及檔案,以免造成損害;此外,臭氧雖可消毒,但也是一種室內環境的重要污染源,且對人體健康和文獻檔案構成危害,故不建議使用。
最後,文獻檔案庫房的空氣污染防治,需貫徹到日常保管及保護工作中,才有利於文獻檔案的保護及工作人員的健康。◇ (完)
參考資料:
[1]荊秀昆,〈大疫面前文獻、檔案工作者如何做好健康保護的同時確保文獻、檔案安全〉,《中國檔案報》,2020.2.17。
micrcr@gmail.com
可揮發性有機化合物治理前、後濃度去除對比表
| 名稱 | 前(ppb) | 後(ppb) | 去除率 | 名稱 | 前(ppb) | 後(ppb) | 去除率 |
| 丙酮 | 5.5 | 5.0 | 9% | 環丙矽氧烷 | 3.0 | 2.0 | 33% |
| 二氯甲烷 | 6.8 | 4.5 | 34% | 乙苯 | 2.4 | 2.0 | 17% |
| 乙酸乙酯 | 3.2 | 2.0 | 38% | 間(對)二甲苯 | 4.6 | 4.5 | 2% |
| 乙酸丙酯 | 2.8 | 2.0 | 29% | α-蒎烯 | 4.0 | 3.5 | 13% |
| 甲苯 | 4.6 | 4.5 | 2% | 2-崁酮 | 12.0 | 5.0 | 58% |